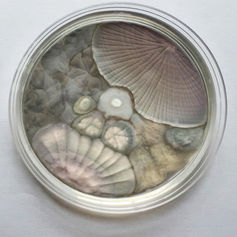

top of page
May 10 - June 12th 2025 Hey There Projects, Joshua Tree CA
Sept 8 - Dec 29th 2024 Getty PST Art&Science Collide Museum of Art and History, Lancaster, CA
Aug - Nov, 2023 Wignall Museum
May 4th - July 4th 2023 Berkeley Art Museum and Pacific Film Archive, Berkeley, CA
Feb 10th - April 1st 2023 ArtWorks Downtown, San Rafael, CA
Feb 9th - 12th 2023 Intersect Palm Springs, CA
Nov 11th - Jan 24th 2023 Madrid Planetarium, Spain
July 16th - Sept 3rd 2022 Lois Lambert Gallery, Santa Monica, CA
March 12 -18th 2022 UC Berkeley Botanical Gardens, CA
Feb 9th - March 9th 2022 Universidad Complutense, Madrid, Spain
Jan 26th - Feb 23rd 2022 Worth Ryder Art Gallery, Berkeley, CA
Jan 15th - April 2022 Cameron Art Museum, Wilmington, North Carolina
November 23rd 2020 Broto Affinity, Climate-Art-Science, online
November 12th - June 30th 2021 Sesnon Gallery and Genomics Institute, online
Feb 4th - 28th 2020 Post Human Publics, RMIT Australia
November 6th-8th 2020 Sigma Xi, Scientific Research Honors Society Art and Film Festival, online
October 18th 2020 International Society for Experimental Artists, Montreal
October 4th 2020 National Endowment of the Arts and Harrison House, online
August 27th 2020 Ecoartspace, online
April 11th 2020 Cal Academy of Sciences, San Francisco, CA
March 27th-31st 2020 Palm Springs Documentary and Animation Festival, CA
March 5th 2020 CalAcademy of Sciences, Women in Science event, SF, CA
December 2nd-15th 2019 COP25 Climate Change Conference, Madrid, Spain
November 20th 2019 Bellas Artes, Madrid, Spain
November 14th, 15th 2019 Norris Center for Natural History, Santa Cruz, CA
November 9th, 10th 2019 Museum of Art and History, Santa Cruz, CA
October 18th 2019 Genomics Institute, Santa Cruz, CA
October 18th - Jan 20th 2019 Black Rock Gallery, Joshua Tree National Park CA
August 2nd, 2019 Institute of Contemporary Art, San Jose CA
May - August, 2019 MOXI, The Wolf Museum of Exploration and Innovation
bottom of page